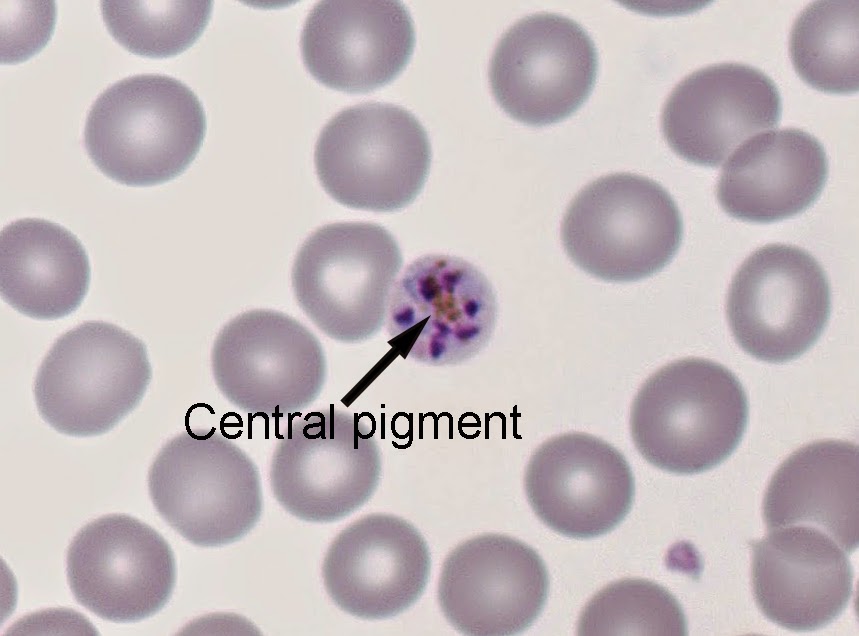

This week's case was generously donated by Dr. Ribes at the University of Kentucky. It's a neat case with an unusual finding.
Photos are taken from an unstained stool concentrate at 100x total magnification. Note that there are 2 sizes of worms present. The largest worms measure 2 mm in length, while the smaller ones are between 200 - 600 micrometers in length.
Representative image of a smaller worm (from a different case):
Monday, February 23, 2015
Sunday, February 22, 2015
Answer to Case 338
Answer: Strongyloides stercoralis - adult female and larvae
This was an unusual case because adult worms were present in the stool specimen, likely correlating with the heavy infection in this patient. Dr. Ribes, who kindly donated this case, resides in one of the rare areas of the United States where strongyloidiasis is still endemic (Kentucky) so she gets to see a fair amount of this infection. She shared with me that she has only seen adults in the stool once or twice in fthe past.
Here is a shot that shows both a larva (probably rhabditiform) and adult female:
This was an unusual case because adult worms were present in the stool specimen, likely correlating with the heavy infection in this patient. Dr. Ribes, who kindly donated this case, resides in one of the rare areas of the United States where strongyloidiasis is still endemic (Kentucky) so she gets to see a fair amount of this infection. She shared with me that she has only seen adults in the stool once or twice in fthe past.
Here is a shot that shows both a larva (probably rhabditiform) and adult female:
Monday, February 16, 2015
Case of the Week 337
The following case was generously donated by Lee. The patient is a 26 year old male with advanced testicular cancer who developed abdominal pain after several rounds of immunosuppressive chemotherapy. A stool specimen submitted for bacterial enteric pathogens culture produced the following pattern on blood agar plate (BAP) and MacConkey (MAC) agar:
BAP
MAC agar
Wet preps from the plate:
BAP
MAC agar
Wet preps from the plate:
Sunday, February 15, 2015
Answer to Case 337
Answer: Strongyloides stercoralis
The blood agar and MacConkey plates clearly show bacterial growth tracks that correlate with the migration of larvae through the agar. As noted by Adam, Florida Fan and Arthur, the small size of the larvae, lack of sheath and short buccal cavity are consistent with the rhabditiform larvae of S. stercoralis. Particularly worrying is the fact that the patient is immunosuppressed and thus is at risk of hyperinfection syndrome. Lee commented that the diagnosis is now known and the patient is receiving treatment, so hopefully he will recover.
Thanks again to Lee for sharing this interesting case with us. It's an important reminder to always be on the look-out for larval tracks on bacterial stool cultures. There are a number of organisms that can cause these tracks including hookworm larvae, free-living nematodes and even arthropods (e.g. mites) and it's therefore important to perform a wet prep from the plate to determine the etiology of the tracks.
The blood agar and MacConkey plates clearly show bacterial growth tracks that correlate with the migration of larvae through the agar. As noted by Adam, Florida Fan and Arthur, the small size of the larvae, lack of sheath and short buccal cavity are consistent with the rhabditiform larvae of S. stercoralis. Particularly worrying is the fact that the patient is immunosuppressed and thus is at risk of hyperinfection syndrome. Lee commented that the diagnosis is now known and the patient is receiving treatment, so hopefully he will recover.
Thanks again to Lee for sharing this interesting case with us. It's an important reminder to always be on the look-out for larval tracks on bacterial stool cultures. There are a number of organisms that can cause these tracks including hookworm larvae, free-living nematodes and even arthropods (e.g. mites) and it's therefore important to perform a wet prep from the plate to determine the etiology of the tracks.
Monday, February 9, 2015
Case of the Week 336
Below are images from an H&E-stained corneal biopsy. The patient had experienced increasing loss of vision and corneal clouding over several months.
100x total magnification
400x total magnification
1000x total magnification
Identification?
100x total magnification
1000x total magnification
Identification?
Sunday, February 8, 2015
Answer to Case 336
Answer: Amebic keratitis, Acanthamoeba species
This case is diagnosed by finding the characteristic cysts and trophozoites of Acanthamoeba. As mentioned by Lukus and Arthur, the trophozoites show a small nucleus with large central nucleolus (karyosome) and the cysts have a characteristic wavy/crenated double wall that give them a 'star-like' appearance. The trophozoite I've shown below may be in the process of excysting since there seems a remnant of the outer double wall present.
Thank you to everyone who wrote in!
This case is diagnosed by finding the characteristic cysts and trophozoites of Acanthamoeba. As mentioned by Lukus and Arthur, the trophozoites show a small nucleus with large central nucleolus (karyosome) and the cysts have a characteristic wavy/crenated double wall that give them a 'star-like' appearance. The trophozoite I've shown below may be in the process of excysting since there seems a remnant of the outer double wall present.
Thank you to everyone who wrote in!
Monday, February 2, 2015
Case of the Week 335
This week's case was kindly donated by Dr. Gary Procop at Cleveland Clinic.
The patient is an otherwise healthy woman in her mid-50's who presented with fever and night sweats. Hematologic exam revealed a mild anemia, leukopenia and thrombocytopenia. The patient travels regularly to Central America and has exposure to exotic wildlife, but none of the animals to which she was exposed were ill.
Identification?
The patient is an otherwise healthy woman in her mid-50's who presented with fever and night sweats. Hematologic exam revealed a mild anemia, leukopenia and thrombocytopenia. The patient travels regularly to Central America and has exposure to exotic wildlife, but none of the animals to which she was exposed were ill.
Identification?
Sunday, February 1, 2015
Answer to Case 335
Answer: Plasmodium malariae
As noted by Florida Fan and Arthur, this case can be identified by the characteristic parasite features including normal to small size of infected RBCs, schizonts with 6-10 merozoites, "rosette" or "daisy" form schizont (merozoites around central hemozoin pigment; see below), and a band-like form. The presence of hemozoin pigment allows us to exclude Babesia sp. from the differential.
As noted by Florida Fan and Arthur, this case can be identified by the characteristic parasite features including normal to small size of infected RBCs, schizonts with 6-10 merozoites, "rosette" or "daisy" form schizont (merozoites around central hemozoin pigment; see below), and a band-like form. The presence of hemozoin pigment allows us to exclude Babesia sp. from the differential.
Subscribe to:
Comments (Atom)